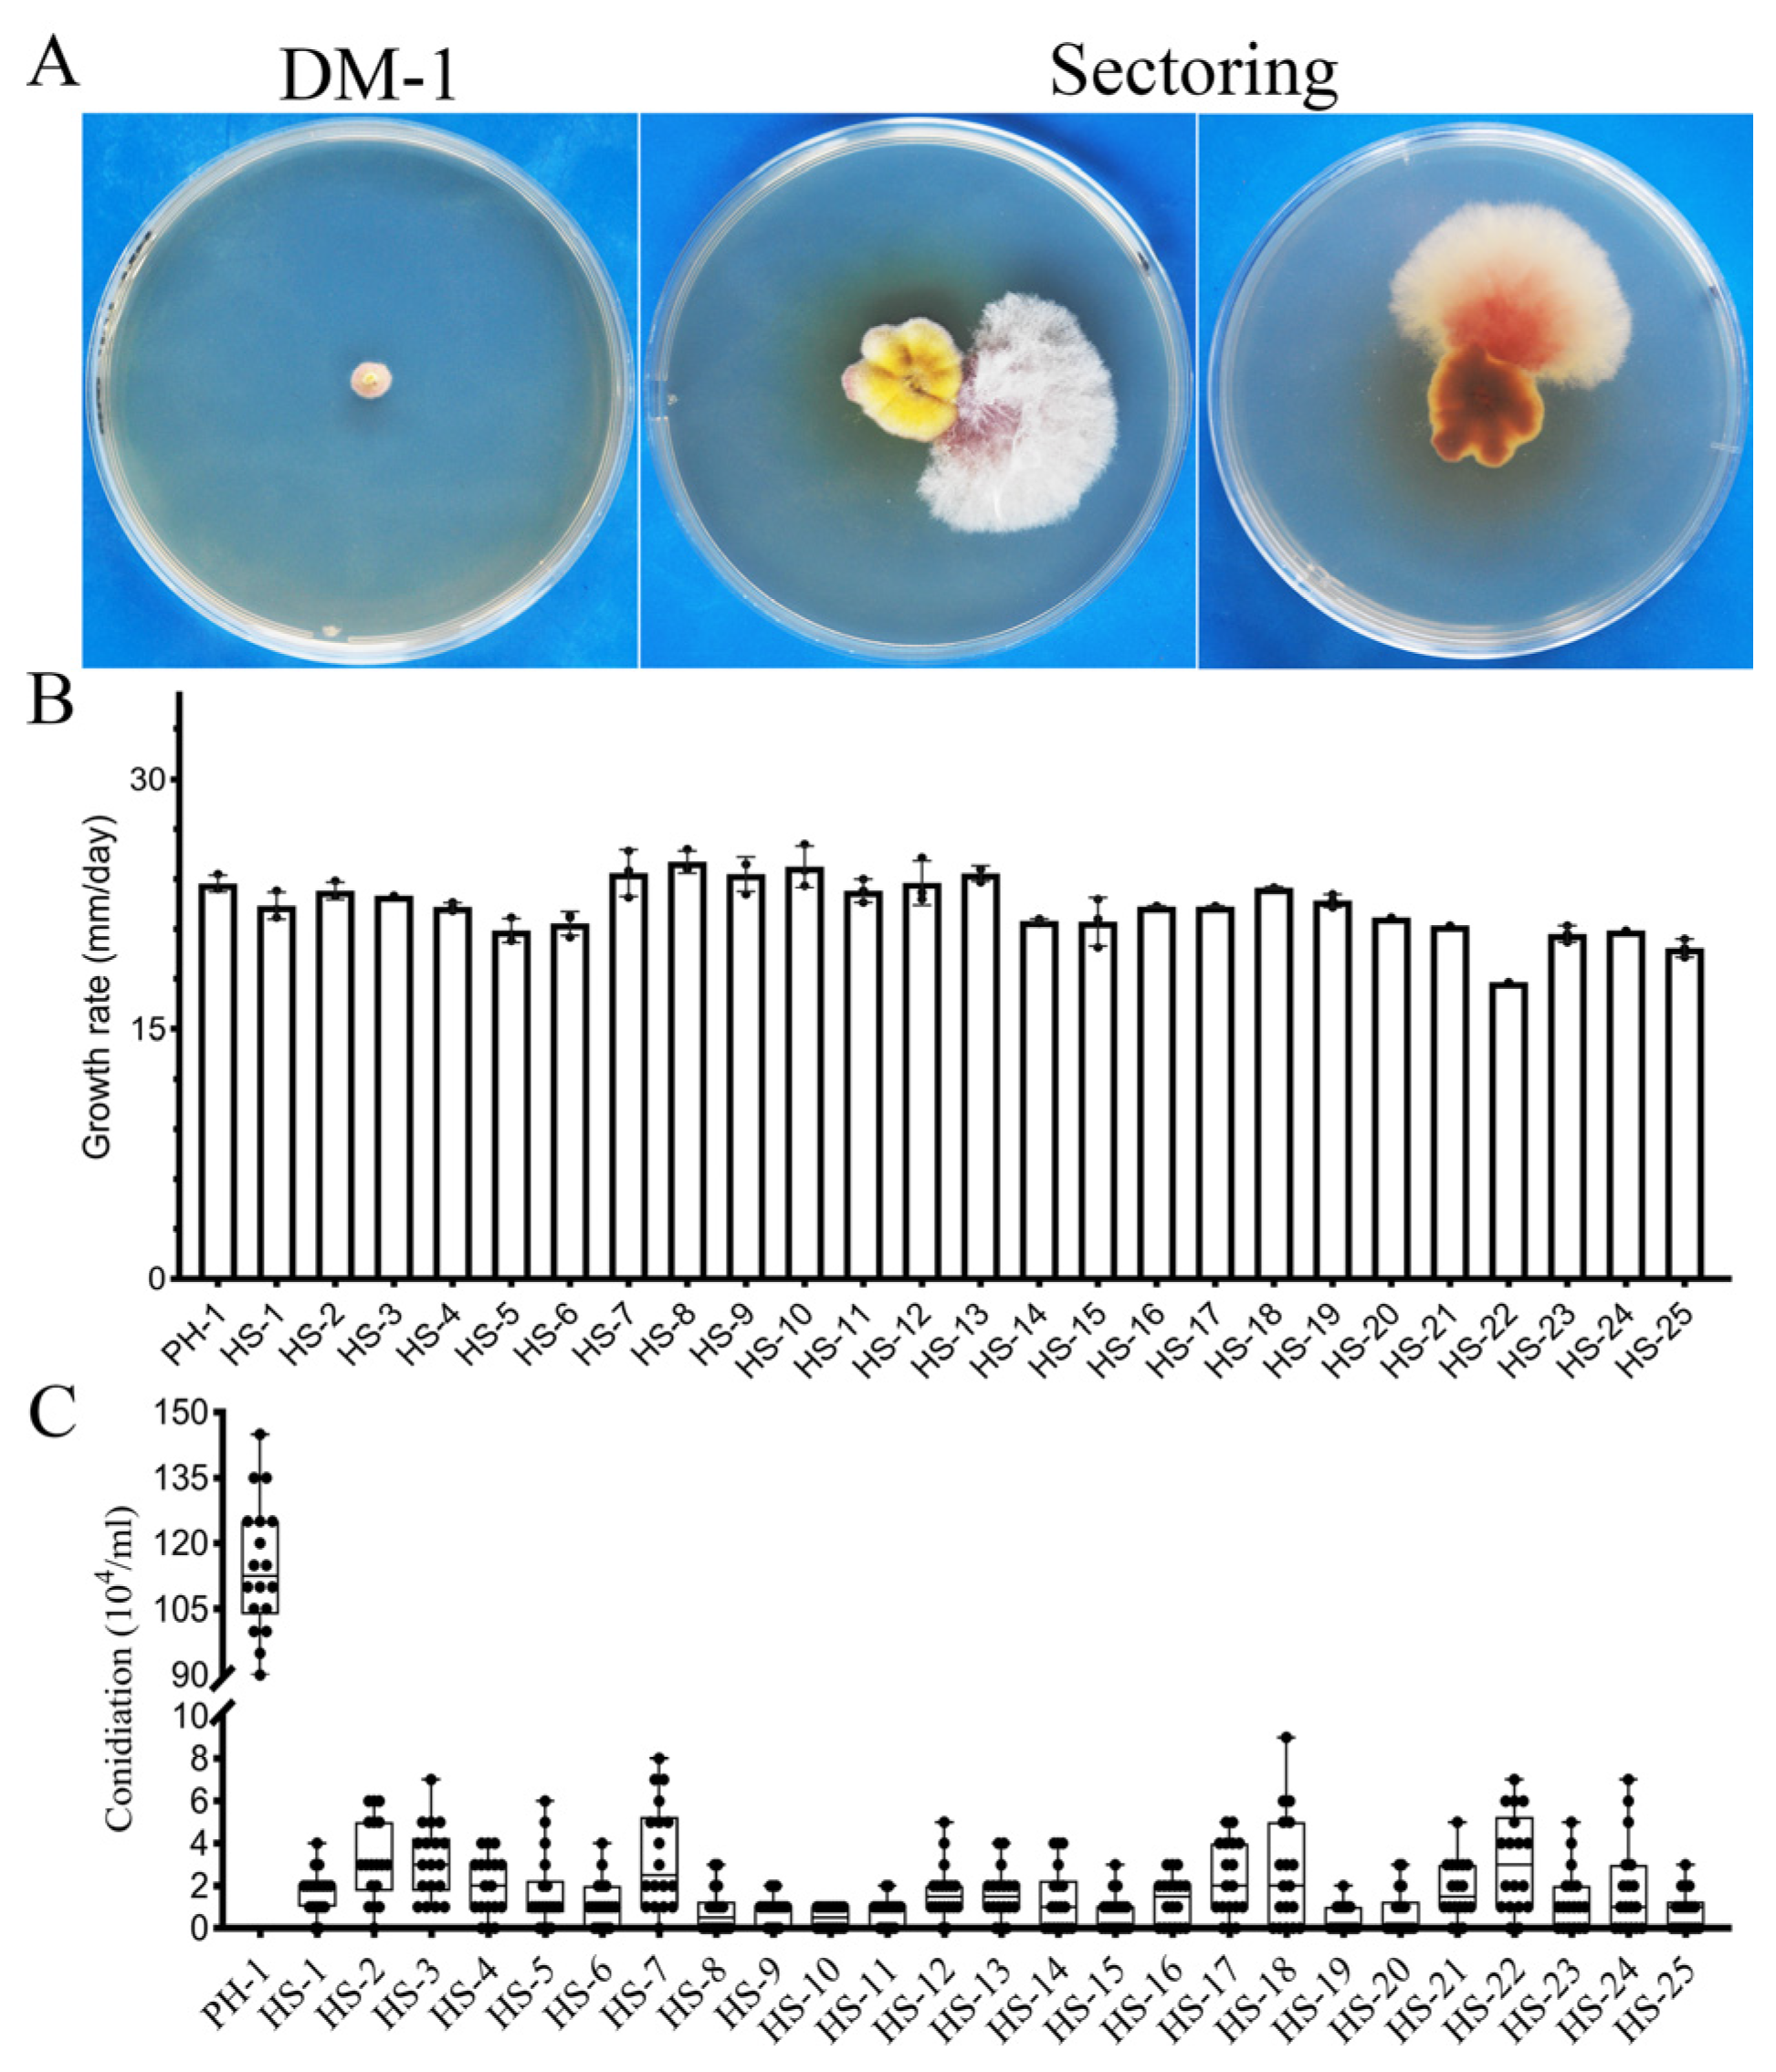
Jof 07 00755 g001

FgSfl1 and Its Conserved PKA Phosphorylation Sites Are Important for Conidiation, Sexual Reproduction, and Pathogenesis in Fusarium graminearum
Abstract
1. Introduction
2. Experimental Procedures
2.1. Spontaneous Suppressors of the cpk1 cpk2 Mutant
2.2. Strains and Culture Conditions
2.3. Generation of Fgsfl1 Deletion Mutant of the cpk1 cpk2 Double Mutant
2.4. Generation of the sfl1 Mutant
2.5. Plant Infection and DON Production Assays
2.6. Sexual Reproduction Assays
2.7. Generation of FgSFL1S223D, FgSFL1T452D, and FgSFL1S559D Transformants of SF-1
2.8. Generation of FgSFL1S223A, FgSFL1T452A, and FgSFL1S559A Transformants of SF-1
2.9. RNA-Seq Analysis
2.10. qRT-PCR Analysis
3. Results
3.1. The CPK1 CPK2 Mutant Is Unstable and Produces Spontaneous Suppressor Strains with Faster Growth Rate
3.2. Suppressors HS-20 and HS-25 Restored Some Asexual and Sexual Reproduction Defects of the cpk1 cpk2 Double Mutant
3.3. Identification of Suppressor Mutations in FgSFL1
3.4. Deletion of FgSFL1 Partially Rescued Defects of the cpk1 cpk2 Double Mutant
3.5. FgSFL1 Is Important for Conidiation and Sexual Reproduction
3.6. FgSFL1 Is Also Important for Infection
3.7. The T452D Mutation in Fgsfl1 Results in Reduced Growth
3.8. The S559D Mutation in Fgsfl1 Affects Conidiation and Sexual Reproduction
3.9. The S-to-A Mutation at S223, T452, or S559 Affects Perithecium Development and Ascospore Release
3.10. Phosphorylation Site in FgSfl1 Essential for Infection
3.11. RNA-Seq Analysis of the Fgsfl1 Mutant
4. Discussion
Supplementary Materials
Author Contributions
Funding
Acknowledgments
Conflicts of Interest
References
- Bai, G.H.; Shaner, G. Management and resistance in wheat and barley to Fusarium head blight. Annu. Rev. Phytopathol. 2004, 42, 135–161. [Google Scholar] [CrossRef]
- Goswami, R.S.; Kistler, H.C. Heading for disaster: Fusarium graminearum on cereal crops. Mol. Plant Pathol. 2004, 5, 515–525. [Google Scholar] [CrossRef] [PubMed]
- Trail, F. For blighted waves of grain: Fusarium graminearum in the postgenomics era. Plant Physiol. 2009, 149, 103–110. [Google Scholar] [CrossRef] [PubMed]
- Dean, R.; Kan, J.A.L.V.; Pretorius, Z.A.; Hammond-Kosack, K.E.; Pietro, A.D.; Spanu, P.D.; Rudd, J.J.; Dickman, M.; Kahmann, R.; Ellis, J.; et al. The top 10 fungal pathogens in molecular plant pathology. Mol. Plant Pathol. 2012, 13, 414–430. [Google Scholar] [CrossRef] [PubMed]
- Desjardins, A.E. Gibberella from A (venaceae) to Z (eae). Annu. Rev. Phytopathol. 2003, 41, 177–198. [Google Scholar] [CrossRef]
- Proctor, R.H.; Hohn, T.M.; McCormick, S.P. Reduced virulence of Gibberella zeae caused by disruption of a trichothecene toxin biosynthetic gene. Mol. Plant-Microbe Interact. 1995, 8, 593–601. [Google Scholar] [CrossRef]
- Jiang, C.; Zhang, C.K.; Wu, C.L.; Sun, P.P.; Hou, R.; Liu, H.Q.; Wang, C.F.; Xu, J.R. TRI6 and TRI10 play different roles in the regulation of deoxynivalenol (DON) production by cAMP signalling in Fusarium graminearum. Environ. Microbiol. 2016, 18, 3689–3701. [Google Scholar] [CrossRef]
- Lee, N.; D’Souza, C.A.; Kronstad, J.W. Of smuts, blasts, mildews, and blights: cAMP signaling in phytopathogenic fungi. Annu. Rev. Phytopathol. 2003, 41, 399–427. [Google Scholar] [CrossRef]
- Kim, C.; Xuong, N.H.; Taylor, S.S. Crystal structure of a complex between the catalytic and regulatory (RIalpha) subunits of PKA. Science 2005, 307, 690–696. [Google Scholar] [CrossRef]
- Xu, J.R.; Urban, M.; Sweigard, J.A.; Hamer, J.E. The CPKA gene of Magnaporthe grisea is essential for appressorial penetration. Mol. Plant-Microbe Interact. 1997, 10, 187–194. [Google Scholar] [CrossRef]
- Pan, X.; Heitman, J. Cyclic AMP-dependent protein kinase regulates pseudohyphal differentiation in Saccharomyces cerevisiae. Mol. Cell Biol. 1999, 19, 4874–4887. [Google Scholar] [CrossRef] [PubMed]
- Maeda, T.; Watanabe, Y.; Kunitomo, H.; Yamamoto, M. Cloning of the pka1 gene encoding the catalytic subunit of the cAMP-dependent protein kinase in Schizosaccharomyces pombe. J. Biol. Chem. 1994, 269, 9632–9637. [Google Scholar] [CrossRef]
- Fuller, K.K.; Richie, D.L.; Feng, X.; Krishnan, K.; Stephens, T.J.; Wikenheiser-Brokamp, K.A.; Askew, D.S.; Rhodes, J.C. Divergent Protein Kinase A isoforms co-ordinately regulate conidial germination, carbohydrate metabolism and virulence in Aspergillus fumigatus. Mol. Microbiol. 2011, 79, 1045–1062. [Google Scholar] [CrossRef] [PubMed]
- Hu, S.; Zhou, X.Y.; Gu, X.Y.; Cao, S.L.; Wang, C.F.; Xu, J.R. The cAMP-PKA pathway regulates growth, sexual and asexual differentiation, and pathogenesis in Fusarium graminearum. Mol. Plant-Microbe Interact. 2014, 27, 557–566. [Google Scholar] [CrossRef] [PubMed]
- Durrenberger, F.; Wong, K.; Kronstad, J.W. Identification of a cAMP-dependent protein kinase catalytic subunit required for virulence and morphogenesis in Ustilago maydis. Proc. Natl. Acad. Sci. USA 1998, 95, 5684–5689. [Google Scholar] [CrossRef] [PubMed]
- Pan, X.; Heitman, J. Protein kinase A operates a molecular switch that governs yeast pseudohyphal differentiation. Mol. Cell Biol. 2002, 22, 3981–3993. [Google Scholar] [CrossRef] [PubMed]
- Li, Y.; Zhang, X.; Hu, S.; Liu, H.; Xu, J.R. Pka activity is essential for relieving the suppression of hyphal growth and appressorium formation by mosfl1 in Magnaporthe oryzae. PLoS Genet. 2017, 13, e1006954. [Google Scholar] [CrossRef]
- Cuomo, C.A.; Guldener, U.; Xu, J.R.; Trail, F.; Turgeon, B.G.; Di Pietro, A.; Walton, J.D.; Ma, L.J.; Baker, S.E.; Rep, M.; et al. The Fusarium graminearum genome reveals a link between localized polymorphism and pathogen specialization. Science 2007, 317, 1400–1402. [Google Scholar] [CrossRef]
- Ding, S.L.; Mehrabi, R.; Koten, C.; Kang, Z.S.; Wei, Y.D.; Seong, K.Y.; Kistler, H.C.; Xu, J.R. Transducin beta-like gene FTL1 is essential for pathogenesis in Fusarium graminearum. Eukaryot. Cell 2009, 8, 867–876. [Google Scholar] [CrossRef]
- Zhou, X.; Li, G.; Xu, J.R. Efficient approaches for generating GFP fusion and epitope-tagging constructs in filamentous fungi. Methods Mol. Biol. 2011, 722, 199–212. [Google Scholar] [CrossRef]
- Hou, Z.M.; Xue, C.Y.; Peng, Y.L.; Katan, T.; Kistler, H.C.; Xu, J.R. A mitogen-activated protein kinase gene (MGV1) in Fusarium graminearum is required for female fertility, heterokaryon formation, and plant infection. Mol. Plant-Microbe Interact. 2002, 15, 1119–1127. [Google Scholar] [CrossRef]
- Bluhm, B.H.; Zhao, X.; Flaherty, J.E.; Xu, J.R.; Dunkle, L.D. RAS2 regulates growth and pathogenesis in Fusarium graminearum. Mol. Plant-Microbe Interact. 2007, 20, 627–636. [Google Scholar] [CrossRef] [PubMed]
- Gale, L.R.; Ward, T.J.; Balmas, V.; Kistler, H.C. Population subdivision of Fusarium graminearum sensu stricto in the upper midwestern United States. Phytopathology 2007, 97, 1434–1439. [Google Scholar] [CrossRef]
- Wang, C.; Zhang, S.; Hou, R.; Zhao, Z.; Zheng, Q.; Xu, Q.; Zheng, D.; Wang, G.; Liu, H.; Gao, X.; et al. Functional analysis of the kinome of the wheat scab fungus Fusarium graminearum. PLoS Pathog. 2011, 7, e1002460. [Google Scholar] [CrossRef]
- Leslie, J.F.; Summerell, B.A.; Bullock, S. The Fusarium Laboratory Manual; Blackwell Publishing: Hoboken, NJ, USA, 2006; ISBN 9780813819198. [Google Scholar]
- Luo, Y.; Zhang, H.; Qi, L.; Zhang, S.; Zhou, X.; Zhang, Y.; Xu, J.R. FgKin1 kinase localizes to the septal pore and plays a role in hyphal growth, ascospore germination, pathogenesis, and localization of Tub1 betatubulins in Fusarium graminearum. New Phytolog. 2014, 204, 943–954. [Google Scholar] [CrossRef]
- Jiang, C.; Zhang, S.; Zhang, Q.; Tao, Y.; Wang, C.; Xu, J.R. FgSKN7 and FgATF1 have overlapping functions in ascosporogenesis, pathogenesis and stress responses in Fusarium graminearum. Environ. Microbiol. 2015, 17, 1245–1260. [Google Scholar] [CrossRef]
- Bruno, K.S.; Tenjo, F.; Li, L.; Hamer, J.E.; Xu, J.R. Cellular localization and role of kinase activity of PMK1 in Magnaporthe grisea. Eukaryot. Cell 2004, 3, 1525–1532. [Google Scholar] [CrossRef] [PubMed]
- King, R.; Urban, M.; Hammond-Kosack, M.C.; Hassani-Pak, K.; Hammond-Kosack, K.E. The completed genome sequence of the pathogenic ascomycete fungus Fusarium graminearum. BMC Genom. 2015, 16, 544. [Google Scholar] [CrossRef]
- Liao, Y.; Smyth, G.K.; Shi, W. featureCounts: An efficient general purpose program for assigning sequence reads to genomic features. Bioinformatics 2014, 30, 923–930. [Google Scholar] [CrossRef] [PubMed]
- Dimont, E.; Shi, J.; Kirchner, R.; Hide, W. EdgeRun: An R package for sensitive, functionally relevant differential expression discovery using an unconditional exact test. Bioinformatics 2015, 31, 2589–2590. [Google Scholar] [CrossRef]
- Ellinger, D.; Sode, B.; Falter, C.; Voigt, C.A. Resistance of callose synthase activity to free fatty acid inhibition as an indicator of Fusarium head blight resistance in wheat. Plant Signal. Behav. 2014, 9, e28982. [Google Scholar] [CrossRef][Green Version]
- Xin, L.; Jiang, J.; Yin, Y.; Ma, Z. Involvement of fgerg4 in ergosterol biosynthesis, vegetative differentiation and virulence in Fusarium graminearum. Mol. Plant Pathol. 2013, 14, 71–83. [Google Scholar] [CrossRef]
- Yun, Y.Z.; Yin, D.F.; Ma, Z. Functional characterization of fgerg3 and fgerg5 associated with ergosterol biosynthesis, vegetative differentiation and virulence of Fusarium graminearum. Fungal Genet. Biol. 2014, 68, 60–70. [Google Scholar] [CrossRef]
- Choi, D.S.; Kim, N.H.; Hwang, B.K. The pepper phosphoenolpyruvate carboxykinase capepck1 is involved in plant immunity against bacterial and oomycete pathogens. Plant Mol. Biol. 2015, 89, 99–111. [Google Scholar] [CrossRef]
- Casperson, G.F.; Walker, N.; Bourne, H.R. Isolation of the gene encoding adenylate cyclase in Saccharomyces cerevisiae. Proc. Natl. Acad. Sci. USA 1985, 82, 5060–5063. [Google Scholar] [CrossRef]
- D’Souza, C.A.; Heitman, J. Conserved cAMP signaling cascades regulate fungal development and virulence. FEMS Microbiol. Rev. 2001, 25, 349–364. [Google Scholar] [CrossRef]
- Maeda, T.; Mochizuki, N.; Yamamoto, M. Adenylyl cyclase is dispensable for vegetative cell growth in the fission yeast Schizosaccharomyces pombe. Proc. Natl. Acad. Sci. USA 1990, 87, 7814–7818. [Google Scholar] [CrossRef]
- Torpdahl, M.; Löfström, C.; Møller Nielsen, E. Whole genome sequencing. Methods Mol. Biol. 2010, 628, 215. [Google Scholar] [CrossRef]
- Atsushi, F.; Yoshiko, K.; Satoru, K.; Yoshio, M.; Shinichi, M.; Harumi, K. Domains of the sfl1 protein of yeasts are homologous to myc oncoproteins or yeast heat-shock transcription factor. Gene 1989, 85, 321–328. [Google Scholar] [CrossRef]
- Fink, R.G.R. The three yeast a kinases have specific signaling functions in pseudohyphal growth. Proc. Natl. Acad. Sci. USA 1998, 95, 13783–13787. [Google Scholar] [CrossRef]
- Li, G.T.; Zhu, X.Y.; Kong, L.A.; Wang, Y.L.; Zhang, H.F.; Zhu, H.; Mitchell, T.K.; Dean, R.A.; Xu, J.R. MoSfl1 is important for virulence and heat tolerance in Magnaporthe oryzae. PLoS ONE 2011, 6, e19951. [Google Scholar] [CrossRef]
- Bauer, J.; Wendland, J. Candida albicans sfl1 suppresses flocculation and filamentation. Eukaryot. Cell 2007, 6, 1736–1744. [Google Scholar] [CrossRef]
- Alexander, N.J.; Proctor, R.H.; Mccormick, S.P. Genes, gene clusters, and biosynthesis of trichothecenes and fumonisins in Fusarium. Toxin Rev. 2009, 28, 198–215. [Google Scholar] [CrossRef]
- Conlan, R.S.; Tzamarias, D. Sfl1 functions via the co-repressor ssn6-tup1 and the camp-dependent protein kinase tpk2. J. Mol. Biol. 2001, 309, 1007–1015. [Google Scholar] [CrossRef] [PubMed]
- Songyang, Z.; Blechner, S.; Hoagland, N.; Hoekstra, M.F.; Piwnica-Worms, H.; Cantley, L.C. Use of an oriented peptide library to determine the optimal substrates of protein kinases. Curr. Biol. 1994, 4, 973–982. [Google Scholar] [CrossRef]
- Wang, Q.H.; Jiang, C.; Wang, C.F.; Chen, C.H.; Xu, J.R.; Liu, H.Q. Characterization of the two-speed subgenomes of Fusarium graminearum reveals the fast-speed subgenome specialized for adaption and infection. Front. Plant Sci. 2017, 8, 140. [Google Scholar] [CrossRef] [PubMed]

| Strains | Brief Description | Reference |
|---|---|---|
| PH-1 | Wild-type | [18] |
| DM-1 | cpk1 cpk2 deletion mutant of PH-1 | [14] |
| DF-18, DF-16, DF-23, DF-25 | Fgsfl1 deletion mutant of DM-1 | This study |
| SF-1, SF-6, SF-39, SF-40, SF-47 | Fgsfl1 deletion mutant of PH-1 | This study |
| CS-1 | Fgsfl1/FgSFL1 complemented transformant | This study |
| P1A-22, P1A-18, P1A-20 | FgSFL1S223A transformant of SF-1 | This study |
| P1M-22, P1M-11, P1M-19 | FgSFL1S223D transformant of SF-1 | This study |
| P2A-14, P2A-10, P2A-8 | FgSFL1T452A transformant of SF-1 | This study |
| P2M-14, P2M-19, P2M-7 | FgSFL1T452D transformant of SF-1 | This study |
| P3M-7, P3M-2, P3M-9 | FgSFL1S559S559D transformant of SF-1 | This study |
| P3A-7, P3A-4, P3A-10 | FgSFL1S559S559A transformant of SF-1 | This study |
| HS-1 to HS-25 | Spontaneous suppressor of DM-1 | This study |
| Strain | Growth Rate (%) | Conidiation (%) | Disease Index | Mutation in SFL1 | |
|---|---|---|---|---|---|
| (%) | Amino Acid | Nucleotide | |||
| PH-1 | 100 | 100 | 100 | wild type | wild type |
| DM-1 | NA | 20.5 | 0 | wild type | wild type |
| HS-1 | 95.4 | 1.5 | 16.4 | K158fs | A531 to ΔA531 |
| HS-2 | 95.4 | 2.8 | 18.9 | Q501 * | C1717 to T1717 |
| HS-3 | 100 | 2.8 | 25.4 | Q501 * | C1717 to T1717 |
| HS-4 | 95.8 | 1.7 | 38.5 | Q501 * | C1717 to T1717 |
| HS-5 | 90.8 | 2.0 | 2.5 | Q501 * | C1717 to T1717 |
| HS-6 | 92.3 | 1.0 | 20.5 | Q501 * | C1717 to T1717 |
| HS-7 | 104.9 | 3.0 | 6.6 | W141 * | G479 to A479 |
| HS-8 | 105.3 | 0.5 | 49.2 | G377fs | Insertion of A at T1347 |
| HS-9 | 102.3 | 0.7 | 49.2 | W198fs | TG759–760 to ΔTG759–760 |
| HS-10 | 102.2 | 0.4 | 21.3 | Q327 * | C1195 to T1195 |
| HS-11 | 100 | 0.5 | 4.9 | Q327 * | C1195 to T1195 |
| HS-12 | 100 | 1.5 | 26.2 | Q501 * | C1717 to T1717 |
| HS-13 | 100 | 1.4 | 49.2 | W198fs | TG759–760 to ΔTG759–760 |
| HS-14 | 95.4 | 1.2 | 31.1 | 141Trp(W) * | G479 to A479 |
| HS-15 | 96.6 | 0.6 | 12.3 | Q501 * | C1717 to T1717 |
| HS-16 | 95.4 | 1.0 | 20.5 | W461 * | G1598 to A1598 |
| HS-17 | 95.4 | 1.2 | 4.1 | Q501 * | C1717 to T1717 |
| HS-18 | 100 | 2.3 | 23.0 | Q501 * | C1717 to T1717 |
| HS-19 | 95.9 | 0.4 | 36.1 | Q501 * | C1717 to T1717 |
| HS-20 | 98 | 0.7 | 59.0 | D335fs | Insertion of A at T1221 |
| HS-21 | 95 | 2.0 | 57.4 | W198fs | TG759–760 to ΔTG759–760 |
| HS-22 | 80.5 | 2.7 | 6.6 | H225N; R490 * | C840 to A840; C1684 to T1684 |
| HS-23 | 90.5 | 1.2 | 6.6 | Q501 * | C1717 to T1717 |
| HS-24 | 90.6 | 1.6 | 27.9 | Q501 * | C1717 to T1717 |
| HS-25 | 96 | 0.7 | 60.7 | Q501 * | C1717 to T1717 |
| Strain | Growth Rate (mm/Day) a,b | Conidiation (×104 Conidia/mL) a,c | Disease Index a,d |
|---|---|---|---|
| PH-1 | 23.4 ± 0.1 A | 105.8 ± 2.2 A | 12 ± 1.9 A |
| SF-1 | 23.0 ± 0.1 A | 1.3 ± 0.3 B | 6 ± 2.2 B |
| CS-1 | 23.3 ± 0.0 A | 108.3 ± 3.0 A | 10 ± 4.0 A |
| DF-18 | 23.4 ± 0.2 A | 0.9 ± 2.1 B | 5 ± 1.6 A |
| HS-20 | 23.1 ± 0.0 A | 0.8 ± 1.1 B | 6 ± 1.0 B |
| HS-25 | 22.4 ± 0.6 A | 0.8 ± 0.9 B | 6 ± 0.57 B |
| P1M-22 | 23.3 ± 0.1 A | 93.3 ± 2.9 A | 8 ± 1.2 B |
| P2M-14 | 20.0 ± 0.2 B | 101.9 ± 1.3 A | 7 ± 1.5 B |
| P3M-7 | 23.0± 0.1 A | 4.2 ± 1.7 B | 6 ± 2.1 B |
| P1A-22 | 23.0 ± 0.1 A | 94.7 ± 4.2 A | 10 ± 1.7 A |
| P2A-14 | 23.0 ± 0.2 A | 108.1 ± 4.6 A | 1 ± 2.4 C |
| P3A-7 | 23.0 ± 0.2 A | 96.7 ± 1.4 A | 10 ± 1.9 A |
Publisher’s Note: MDPI stays neutral with regard to jurisdictional claims in published maps and institutional affiliations. |
© 2021 by the authors. Licensee MDPI, Basel, Switzerland. This article is an open access article distributed under the terms and conditions of the Creative Commons Attribution (CC BY) license (https://creativecommons.org/licenses/by/4.0/).
Share and Cite
Gong, C.; Huang, J.; Sun, D.; Xu, D.; Guo, Y.; Kang, J.; Niu, G.; Wang, C. FgSfl1 and Its Conserved PKA Phosphorylation Sites Are Important for Conidiation, Sexual Reproduction, and Pathogenesis in Fusarium graminearum. J. Fungi 2021, 7, 755. https://doi.org/10.3390/jof7090755
Gong C, Huang J, Sun D, Xu D, Guo Y, Kang J, Niu G, Wang C. FgSfl1 and Its Conserved PKA Phosphorylation Sites Are Important for Conidiation, Sexual Reproduction, and Pathogenesis in Fusarium graminearum. Journal of Fungi. 2021; 7(9):755. https://doi.org/10.3390/jof7090755
Chicago/Turabian StyleGong, Chen, Junqi Huang, Daiyuan Sun, Daiying Xu, Yuqian Guo, Jiangang Kang, Gang Niu, and Chenfang Wang. 2021. "FgSfl1 and Its Conserved PKA Phosphorylation Sites Are Important for Conidiation, Sexual Reproduction, and Pathogenesis in Fusarium graminearum" Journal of Fungi 7, no. 9: 755. https://doi.org/10.3390/jof7090755
APA StyleGong, C., Huang, J., Sun, D., Xu, D., Guo, Y., Kang, J., Niu, G., & Wang, C. (2021). FgSfl1 and Its Conserved PKA Phosphorylation Sites Are Important for Conidiation, Sexual Reproduction, and Pathogenesis in Fusarium graminearum. Journal of Fungi, 7(9), 755. https://doi.org/10.3390/jof7090755

